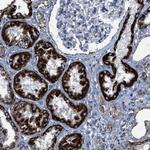
ALDH1B1 Antibody in Immunohistochemistry (Paraffin) (IHC (P))

Search
Invitrogen
ALDH1B1 Polyclonal Antibody
{{$productOrderCtrl.translations['antibody.pdp.commerceCard.promotion.promotions']}}
{{$productOrderCtrl.translations['antibody.pdp.commerceCard.promotion.viewpromo']}}
{{$productOrderCtrl.translations['antibody.pdp.commerceCard.promotion.promocode']}}: {{promo.promoCode}} {{promo.promoTitle}} {{promo.promoDescription}}. {{$productOrderCtrl.translations['antibody.pdp.commerceCard.promotion.learnmore']}}

Please note: We are reviewing Western blot images included in the antibody testing data in our catalog, including those provided by third parties. Unless expressly labeled or annotated as “raw-unedited”, Western blot images included in the antibody testing data in our catalog may have been edited, optimized or otherwise adjusted for presentation.
产品信息
PA5-54314
种属反应
宿主/亚型
分类
类型
抗原
偶联物
形式
浓度
规格
纯化类型
保存液
内含物
保存条件
运输条件
RRID
产品详细信息
Immunogen sequence: MLRFLAPRLL SLQGRTARYS SAAALPSPIL NPDIPYNQLF INNEWQDAVS KKTFPTVNPT TGEVIGHV
Highest antigen sequence identity to the following orthologs: Mouse - 79%, Rat - 82%.
靶标信息
Aldehyde dehydrogenases (ALDHs) mediate NADP+-dependent oxidation of aldehydes into acids during detoxification of alcohol-derived acetaldehyde, lipid peroxidation and metabolism of corticosteroids, biogenic amines and neurotransmitters. Alcohol drinking habits and cardiovascular disease risk factors may be associated with ALDH gene variants. ALDH1B1 (Aldehyde dehydrogenase family 1 member B1), also known as ALDH5 or ALDHX (Aldehyde dehydrogenase X, mitochondrial), is a 517 amino acid mitochondrial protein that is expressed in the liver, testis and to a lesser extent in brain. ALDH1B1 belongs to the aldehyde dehydrogenase family and may play a major role in ethanol detoxification.
仅用于科研。不用于诊断过程。未经明确授权不得转售。
篇参考文献 (0)
生物信息学
蛋白别名: Aldehyde dehydrogenase 5; Aldehyde dehydrogenase family 1 member B1; Aldehyde dehydrogenase X, mitochondrial; MGC2230
基因别名: ALDH1B1; ALDH5; ALDHX
Entrez Gene ID: (Human) 219




